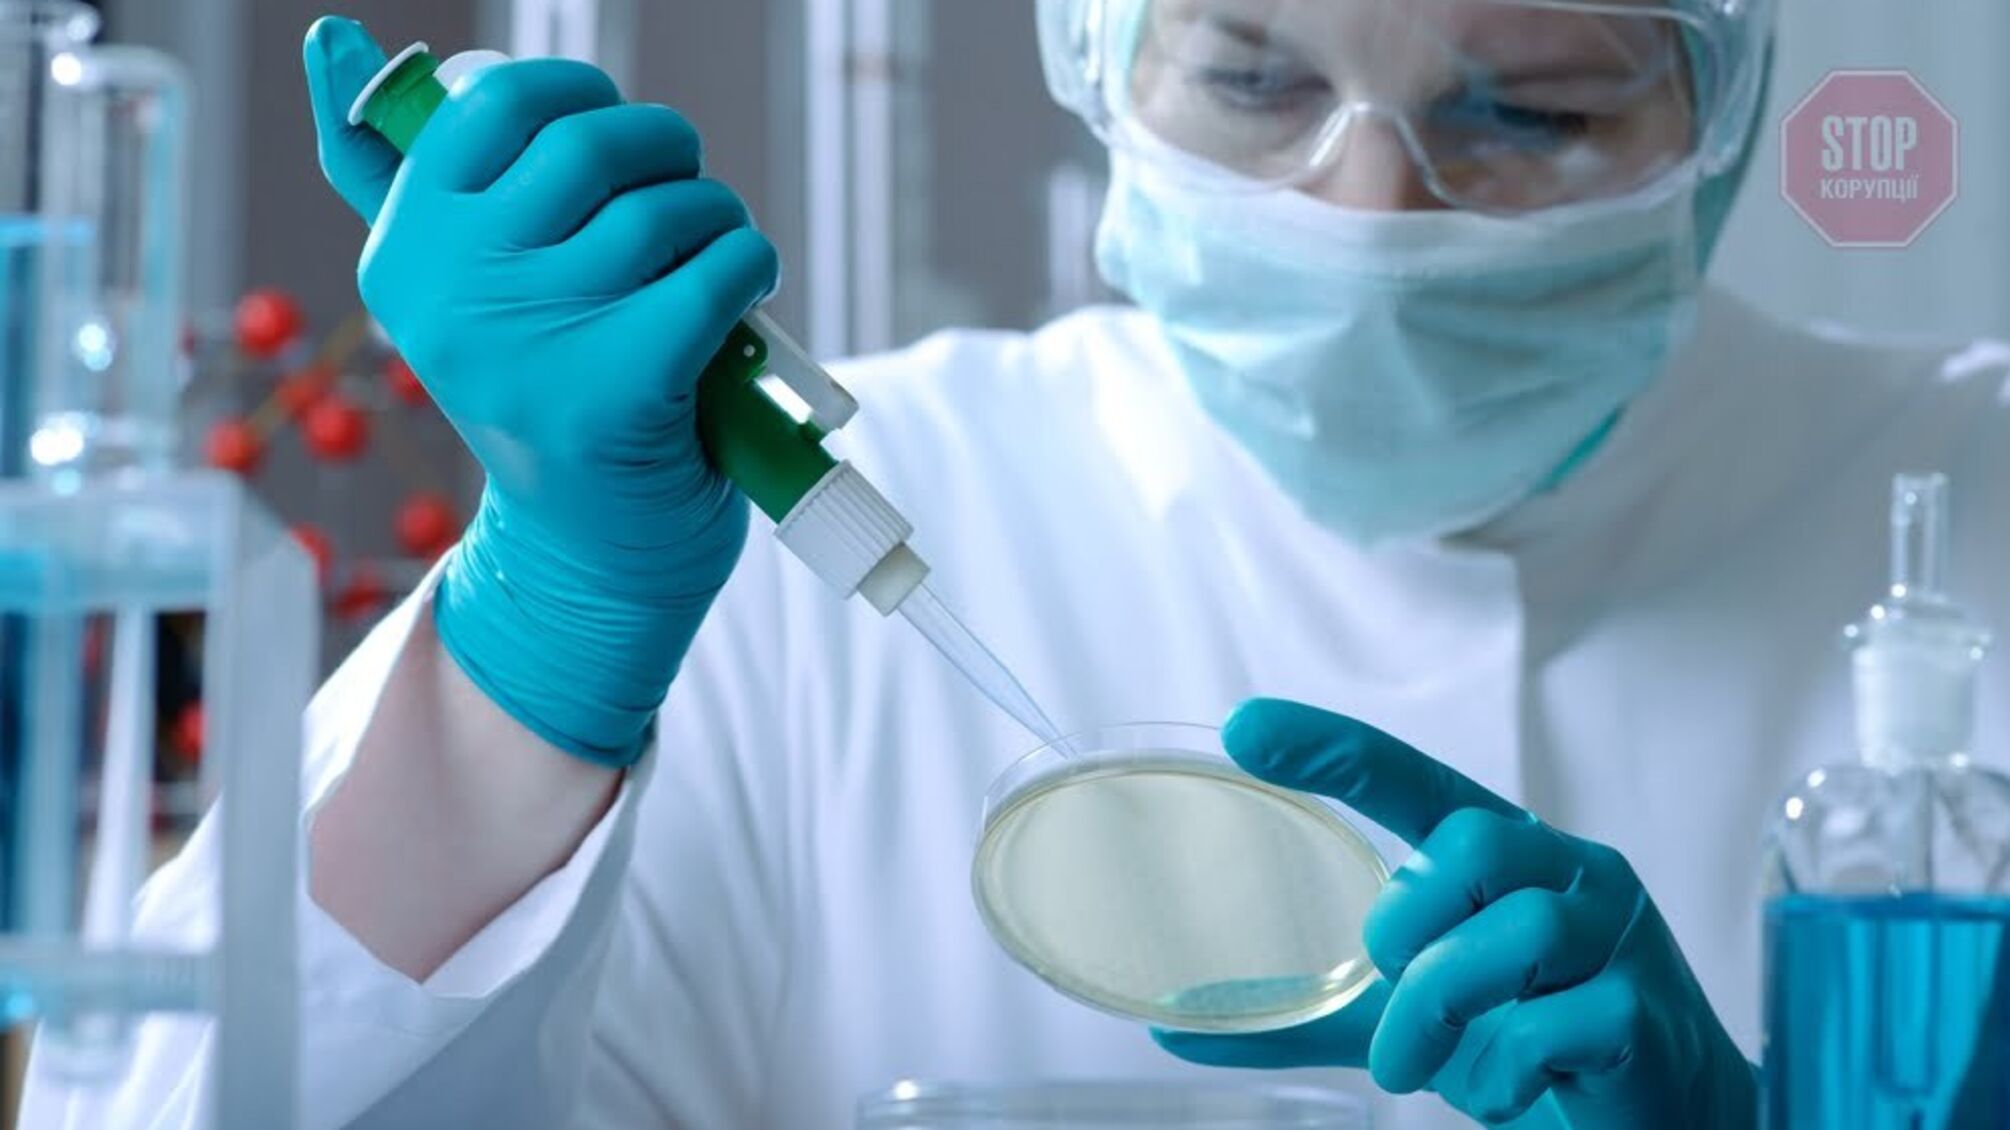
На Дніпропетровщині чоловік помер через консервовану свинину – подробиці

У Кривому Розі 59-річний чоловік помер через консервовану свинину. Причиною виявився ботулізм.
Чоловік потрапив до лікарні з ознаками отруєння, але фахівці встановили - він заразився ботулізмом.
Як повідомляє Управління охорони здоров'я виконкому Криворізької міськради, напередодні госпіталізації він вживав консервовану свинину домашнього приготування.
Чоловікові провели три операції і ввели сироватку, але це не допомогло - інфекція вразила життєво важливі органи, передає "Новий формат".






